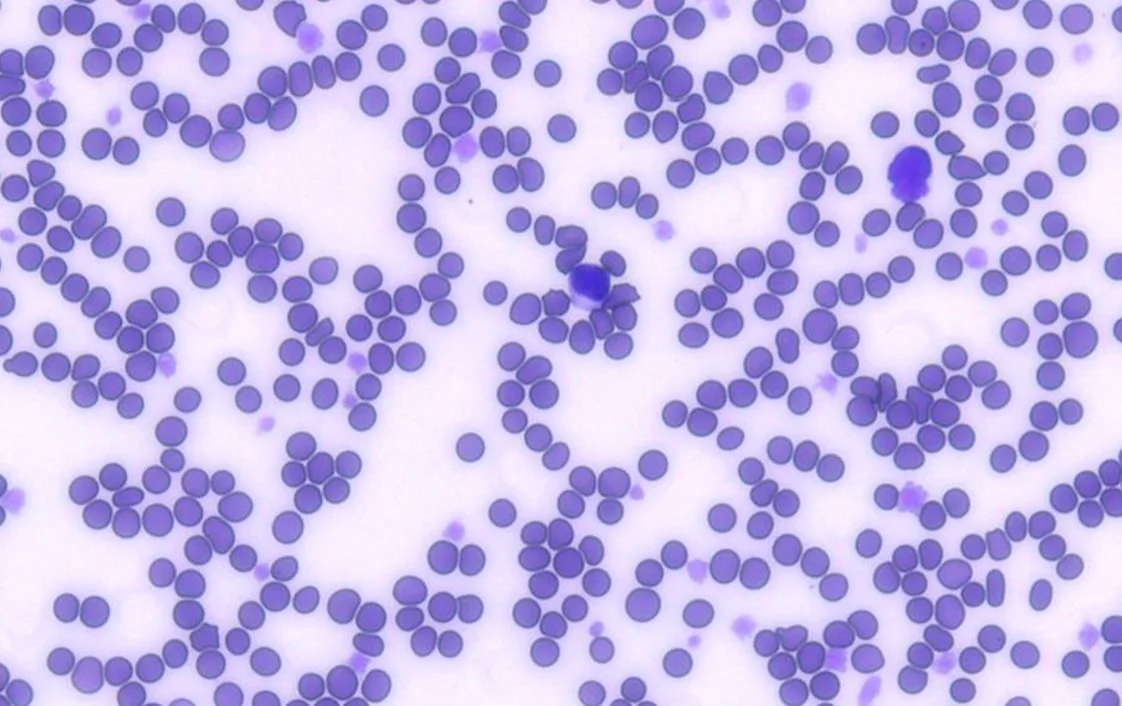

Pathview
AI CBC Analyzer Validation
White Blood Cell Count Validation Study
Complete blood count performance in veterinary diagnostics
Validation study comparing automated WBC counts from the Moichor Pathview AI system against manual counts by veterinary pathologists.
r² = 0.9996

The AI counts white blood cells with almost perfect accuracy to experienced veterinary pathologists. Exceptional agreement between automated and expert human analysis across all 93 samples. Results are as reliable as those from a board-certified pathologist.




Samples
93 monolayer blood smears from veterinary patients were analyzed with both AI and manual pathologist review.
Board-certified veterinary pathologists manually counted WBCs using standardized microscopic protocols.
Reference Standard
AI Analysis
The Pathview system automatically identified and counted WBCs using trained deep learning algorithms.
Statistical Analysis
Pearson correlation analysis to determine the coefficient of determination (r²).
Exceptional correlation achieved.
93 samples analyzed • AI vs Pathologist Comparison
What these results mean.
The AI counts white blood cells with identical accuracy to experienced veterinary pathologists
Exceptional agreement between automated and expert human analysis across all 93 samples
Eliminates counting errors and reduces analysis time while maintaining gold-standard quality.
Provides consistent, reproducible results for enhanced diagnostic confidence.
AI-powered Cell Identification Validation

Pathview's AI-powered cell identification was validated against clinical pathologist review as the ground truth standard. The system demonstrated strong agreement across all white blood cell populations.
Cell Line Accuracy
90%
Neutrophils
90%
Lymphocytes
90%
Monocytes
Species Validated



97%
Band Neutrophils
100%
Basophils
87%
Eosinophils
Results
92
Total Samples Analyzed
92.4%
Mean Accuracy Achieved
Canine/Feline
What these results mean.

Pathview delivers accuracy across all major white blood cell populations with mean performance of 92.4%
Demonstrates exceptional band cell identification capabilities critical for comprehensive CBC analysis.
High band neutrophil accuracy supports reliable left shift assessment.
Consistent cross-species performance validates use in both canine and feline clinical settings.
Ready to transform your clinic's diagnostics?
Get reliable, fast results that save time and improve patient care decisions.
